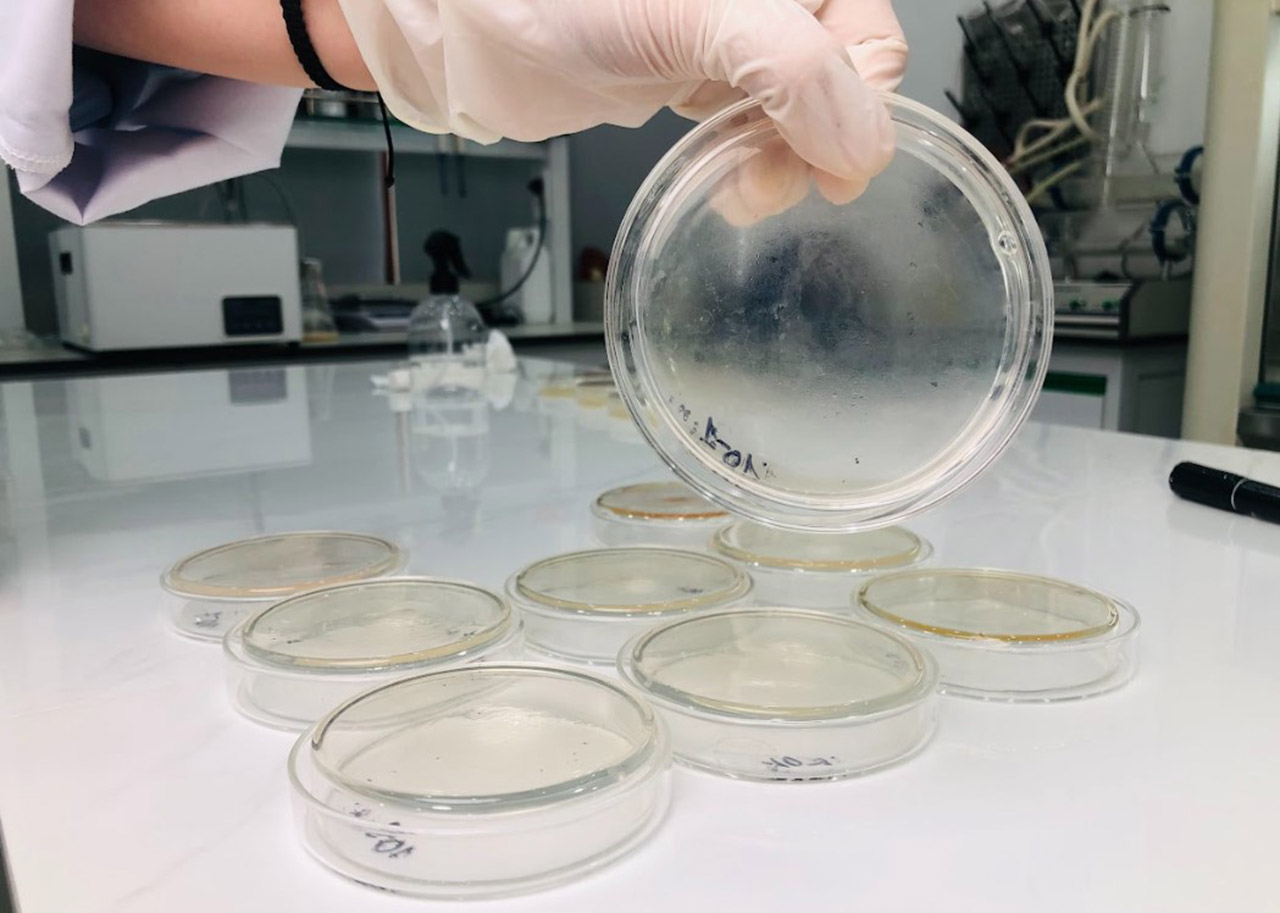
Ch&acirc;u Kh&ocirc;i Pharma kiểm nghiệm chất lượng trong ph&ograve;ng th&iacute; nghiệm

Gia công TPBVSK giá rẻ có an toàn không? Góc nhìn khoa học & pháp lý

Gia công TPBVSK giá rẻ có an toàn không là băn khoăn phổ biến của nhiều doanh nghiệp khi muốn nhanh chóng đưa sản phẩm ra thị trường với chi phí thấp. Tuy nhiên, dưới góc nhìn khoa học và pháp lý, mức giá gia công thấp chỉ phản ánh chi phí hồ sơ và sản xuất tối thiểu, chứ không đảm bảo giá trị sinh học hay mức độ an toàn lâu dài cho người sử dụng. Thực tế cho thấy, không ít sản phẩm đúng luật tại thời điểm công bố nhưng lại tiềm ẩn rủi ro trong suốt vòng đời lưu hành, đặc biệt khi hiệu quả sinh học suy giảm hoặc không đạt như kỳ vọng ban đầu.
Giá rẻ có thể đúng luật nhưng không an toàn dài hạn
Trong gia công thực phẩm chức năng, việc tuân thủ quy định pháp lý giúp sản phẩm được phép lưu hành, nhưng không đồng nghĩa với an toàn và hiệu quả bền vững. Nhiều đơn vị gia công tối ưu giá bằng cách lựa chọn hàm lượng hoạt chất ở mức tối thiểu, cắt giảm overage hoặc bỏ qua các giải pháp ổn định công thức. Điều này khiến sản phẩm tuy không vi phạm quy định nhưng dễ suy giảm chất lượng theo thời gian, làm tăng rủi ro khi sử dụng lâu dài.
Sự khác biệt giữa an toàn hồ sơ và an toàn sinh học
An toàn hồ sơ là khái niệm mang tính pháp lý, tập trung vào giấy tờ, tiêu chuẩn công bố và kết quả kiểm nghiệm tại một thời điểm nhất định. Trong khi đó, an toàn sinh học liên quan trực tiếp đến khả năng sản phẩm duy trì tác dụng, không phát sinh rủi ro trong suốt quá trình bảo quản và sử dụng. Một sản phẩm chỉ an toàn trên hồ sơ nhưng không ổn định về sinh học có thể gây thất vọng cho người dùng và ảnh hưởng nghiêm trọng đến uy tín thương hiệu.
Vì sao giá gia công thấp thường đi kèm rủi ro ẩn
Giá gia công thấp thường được hình thành từ việc giảm chi phí ở những khâu khó nhìn thấy, như chất lượng nguyên liệu, hàm lượng hoạt chất, kiểm soát oxy hóa hoặc kiểm nghiệm cuối hạn. Những yếu tố này không dễ nhận biết ngay từ đầu nhưng lại quyết định hiệu quả thực tế của sản phẩm khi lưu hành trên thị trường. Do đó, rủi ro khi gia công thực phẩm chức năng giá rẻ thường chỉ bộc lộ sau một thời gian sử dụng, khi doanh nghiệp đã tốn kém nhiều chi phí marketing và xây dựng thương hiệu.
Vấn đề cốt lõi khi gia công TPBVSK mà doanh nghiệp thường hiểu sai

Nhiều doanh nghiệp bước vào lĩnh vực TPBVSK với suy nghĩ rằng chỉ cần hoàn tất hồ sơ pháp lý là đủ. Cách tiếp cận này vô tình khiến quá trình gia công tập trung vào “đúng luật” thay vì “đúng giá trị”, dẫn đến những sai lầm mang tính hệ thống trong phát triển sản phẩm.
Đúng pháp lý chỉ là điều kiện cần
Tuân thủ pháp lý giúp sản phẩm được phép lưu hành, nhưng không đảm bảo sản phẩm mang lại giá trị sử dụng thực sự. Nếu chỉ dừng lại ở mức đúng luật, doanh nghiệp rất khó cạnh tranh trong bối cảnh người tiêu dùng ngày càng quan tâm đến hiệu quả và trải nghiệm thực tế.
Tác dụng sinh học thực sự mới là giá trị cốt lõi
Giá trị của một sản phẩm TPBVSK nằm ở tác dụng sinh học mà người dùng cảm nhận được, không phải ở số lượng thành phần liệt kê trên nhãn. R&D bài bản cần đảm bảo hoạt chất đạt ngưỡng sinh học, có hiệp đồng hợp lý và phát huy hiệu quả rõ ràng trong điều kiện sử dụng thực tế.
Hiệu quả phải duy trì đến cuối hạn sử dụng, không chỉ lúc công bố
Nhiều sản phẩm đạt kiểm nghiệm tốt tại thời điểm công bố nhưng hiệu quả suy giảm mạnh về cuối hạn. Điều này cho thấy sự thiếu hụt trong chiến lược overage, ổn định công thức và kiểm soát chất lượng dài hạn - yếu tố then chốt để sản phẩm tồn tại bền vững trên thị trường.
Phân biệt các khái niệm dễ nhầm lẫn trong gia công thực phẩm chức năng

Để tránh rủi ro khi gia công thực phẩm chức năng, doanh nghiệp cần hiểu đúng những khái niệm thường bị đánh đồng trong quá trình lựa chọn đơn vị gia công và xây dựng sản phẩm.
Đúng pháp lý ≠ Có tác dụng sinh học
Sản phẩm đáp ứng đầy đủ quy định pháp luật chưa chắc đã mang lại hiệu quả sinh học rõ ràng. Tác dụng thực sự phụ thuộc vào hàm lượng, chất lượng và khả năng hấp thu của hoạt chất, không chỉ vào hồ sơ công bố.
Có thành phần ≠ Có hiệu quả
Việc liệt kê nhiều thành phần trên nhãn không đảm bảo sản phẩm hiệu quả. Nếu các hoạt chất không đạt ngưỡng sinh học hoặc không có hiệp đồng hợp lý, sản phẩm vẫn có thể kém tác dụng dù công thức nhìn rất “đẹp”.
Giá rẻ ≠ Tối ưu chi phí thực sự
Giá gia công thấp chỉ giúp giảm chi phí ban đầu, nhưng chi phí thực sự còn bao gồm chi phí marketing, xử lý khiếu nại, rủi ro pháp lý và tổn thất thương hiệu. Một chiến lược tối ưu đúng nghĩa là tối ưu tổng chi phí vòng đời sản phẩm, không phải chỉ nhìn vào giá gia công ban đầu.
Để được Châu Khôi Pharma hỗ trợ tư vấn chuyên sâu Giá gia công thấp đến từ đâu? Gia công tử tế khó hơn gia công rẻ ở điểm nào?, vui lòng liên hệ hotline 0904 836 693 hoặc Fanpage Châu Khôi Pharma (https://www.facebook.com/chaukhoipharma/) để được đội ngũ chuyên gia R&D, QC, QA hàng đầu ngành TPBVSK trực tiếp đồng hành và tư vấn giải pháp phù hợp, an toàn và bền vững cho doanh nghiệp.
Thế nào là một sản phẩm TPBVSK có tác dụng sinh học thật?
Một sản phẩm TPBVSK chỉ được xem là có tác dụng sinh học thật khi hiệu quả của nó được hình thành từ nền tảng khoa học vững chắc, có thể đo lường, duy trì và kiểm chứng trong suốt vòng đời sử dụng. Dưới góc nhìn R&D và kiểm soát chất lượng, tác dụng sinh học không đến từ số lượng thành phần hay câu chữ quảng bá, mà đến từ ngưỡng hoạt chất, sự hiệp đồng và độ ổn định dài hạn của công thức.
Hoạt chất đạt ngưỡng sinh học tối thiểu
Hoạt chất chỉ phát huy tác dụng khi đạt ngưỡng sinh học cần thiết, tức hàm lượng đủ để tạo ra đáp ứng sinh học trong cơ thể. Việc sử dụng hàm lượng thấp hơn ngưỡng này có thể không vi phạm pháp lý, nhưng khiến sản phẩm gần như không mang lại hiệu quả thực tế cho người dùng.
Có hiệp đồng sinh học, không chồng chéo vô nghĩa
Một công thức hiệu quả cần được thiết kế dựa trên sự hiệp đồng giữa các hoạt chất, giúp tăng cường khả năng hấp thu và tác dụng lẫn nhau. Ngược lại, việc đưa nhiều thành phần không liên quan hoặc trùng lặp cơ chế tác động chỉ làm công thức “đẹp trên nhãn”, nhưng không cải thiện hiệu quả sinh học.
Ổn định chất lượng trong suốt vòng đời sản phẩm
Tác dụng sinh học thật không chỉ xuất hiện ở thời điểm sản xuất mà phải được duy trì ổn định từ đầu đến cuối hạn sử dụng. Điều này đòi hỏi giải pháp về công nghệ bào chế, bao gói và kiểm soát các yếu tố gây phân hủy như ánh sáng, độ ẩm và oxy.
Đạt kiểm nghiệm tại thời điểm cuối hạn sử dụng
Một sản phẩm đạt kiểm nghiệm ban đầu chưa đủ để khẳng định chất lượng. Kiểm nghiệm ở cuối hạn sử dụng là minh chứng quan trọng cho thấy sản phẩm vẫn duy trì hàm lượng và hiệu quả như đã công bố, giảm thiểu rủi ro cho cả người tiêu dùng và doanh nghiệp.
Giá bán phản ánh đúng giá trị khoa học bên trong
Giá bán của sản phẩm TPBVSK có tác dụng sinh học thật thường tương xứng với chi phí R&D, nguyên liệu và kiểm soát chất lượng. Mức giá quá thấp so với mặt bằng chung có thể là dấu hiệu cho thấy giá trị khoa học bên trong đã bị cắt giảm.
Rủi ro khi gia công thực phẩm chức năng giá rẻ doanh nghiệp phải đối mặt

Gia công thực phẩm chức năng giá rẻ thường hấp dẫn ở chi phí ban đầu thấp, nhưng lại tiềm ẩn nhiều rủi ro dài hạn mà doanh nghiệp chỉ nhận ra khi sản phẩm đã lưu hành trên thị trường. Những rủi ro này không chỉ ảnh hưởng đến hiệu quả kinh doanh mà còn tác động trực tiếp đến uy tín thương hiệu.
Suy giảm hàm lượng hoạt chất theo thời gian
Khi không có chiến lược overage và ổn định công thức, hàm lượng hoạt chất dễ suy giảm nhanh trong quá trình bảo quản, khiến sản phẩm không còn đạt mức công bố về cuối hạn sử dụng.
Hiệu quả thực tế thấp → khó bán lại
Sản phẩm kém hiệu quả dẫn đến trải nghiệm người dùng không tốt, tỷ lệ mua lại thấp. Điều này khiến doanh nghiệp phải tăng chi phí marketing nhưng vẫn khó duy trì doanh số bền vững.
Nguy cơ hậu kiểm, thu hồi, xử phạt
Khi sản phẩm không đạt chất lượng tại thời điểm hậu kiểm, doanh nghiệp có thể đối mặt với thu hồi, xử phạt hoặc đình chỉ lưu hành, gây thiệt hại lớn về tài chính và pháp lý.
Thương hiệu ngắn hạn, không thể scale
Những sản phẩm được xây dựng trên nền tảng giá rẻ và hiệu quả thấp thường chỉ tồn tại ngắn hạn, khó mở rộng quy mô hoặc phát triển thành thương hiệu mạnh trong ngành TPBVSK.
Cảnh báo xu hướng “ăn gian sinh học” trong gia công TPBVSK hiện nay

“Ăn gian sinh học” là xu hướng nguy hiểm trong gia công TPBVSK, khi giá thành được tối ưu bằng cách cắt giảm giá trị sinh học cốt lõi của sản phẩm. Dù không vi phạm pháp lý ngay lập tức, xu hướng này tiềm ẩn nhiều hệ lụy cho cả doanh nghiệp và người tiêu dùng.
Giảm hàm lượng hoạt chất đắt tiền
Để hạ giá gia công, nhiều đơn vị lựa chọn giảm hoặc thay thế các hoạt chất có giá trị cao, khiến hiệu quả sản phẩm suy giảm đáng kể so với kỳ vọng ban đầu.
Không overage - không sai luật nhưng sai đạo đức nghề
Việc không áp dụng overage giúp tiết kiệm chi phí, nhưng đồng nghĩa với việc không đảm bảo hàm lượng hoạt chất đến cuối hạn, đi ngược lại trách nhiệm nghề nghiệp trong ngành chăm sóc sức khỏe.
Không giải pháp chống oxy hóa - phân hủy
Thiếu các giải pháp chống oxy hóa và bảo vệ công thức khiến hoạt chất dễ bị phân hủy trong quá trình lưu kho, làm giảm tác dụng sinh học ngay cả khi sản phẩm chưa hết hạn.
Hệ quả: sản phẩm yếu, marketing càng mạnh càng rủi ro
Khi sản phẩm thiếu giá trị thực, việc đẩy mạnh marketing chỉ làm khuếch đại rủi ro, gia tăng khiếu nại, hoàn trả và khủng hoảng truyền thông, gây tổn hại lâu dài cho thương hiệu.
Quan điểm chuyên gia: Vì sao sản phẩm TPBVSK bền vững không cần lách luật?
Từ góc nhìn của các chuyên gia R&D và kiểm soát chất lượng, một sản phẩm TPBVSK thực sự bền vững không cần dựa vào việc lách luật hay tận dụng kẽ hở pháp lý để tồn tại. Khi nền tảng sinh học và chất lượng được xây dựng đúng ngay từ đầu, sản phẩm có thể đứng vững trên thị trường bằng chính hiệu quả thực tế, giảm thiểu rủi ro và tạo dư địa phát triển dài hạn cho doanh nghiệp.
Sản phẩm tốt tự bán được, ít phụ thuộc quảng cáo
Sản phẩm có tác dụng sinh học rõ ràng giúp người tiêu dùng cảm nhận được hiệu quả thật, từ đó hình thành niềm tin và hành vi mua lại. Khi giá trị cốt lõi đủ mạnh, doanh nghiệp không cần phụ thuộc quá nhiều vào quảng cáo ngắn hạn hay thông điệp phóng đại.
Ít khủng hoảng, ít rủi ro pháp lý
Những sản phẩm được phát triển bài bản thường ít vướng tranh chấp, khiếu nại và rủi ro hậu kiểm. Việc tuân thủ cả pháp lý lẫn chuẩn mực khoa học giúp doanh nghiệp tránh được các đợt thu hồi, xử phạt hoặc khủng hoảng truyền thông không đáng có.
Dễ xây dựng thương hiệu dài hạn 5-10 năm
Thương hiệu TPBVSK chỉ có thể phát triển bền vững khi sản phẩm được thị trường công nhận về hiệu quả và độ an toàn. Đây là nền tảng để doanh nghiệp mở rộng danh mục sản phẩm, xây dựng uy tín và duy trì tăng trưởng ổn định trong 5-10 năm hoặc lâu hơn.
Khách hàng quan tâm đến công bố và đăng kí sản phẩm vui lòng liên hệ: https://yduocchaukhoi.com/lien-he Điền thông tin vào form đăng ký để được hỗ trợ tư vấn dịch vụ và chương trình ưu đãi tốt nhất!
Doanh nghiệp cần kiểm tra gì trước khi ký hợp đồng gia công TPBVSK?
Trước khi quyết định hợp tác gia công TPBVSK, doanh nghiệp cần tiếp cận vấn đề theo hướng kiểm soát rủi ro từ đầu, thay vì chỉ quan tâm đến chi phí hay thời gian ra sản phẩm. Một checklist rõ ràng sẽ giúp tránh những sai lầm khó khắc phục về sau.
Công thức & hàm lượng có minh bạch không?
Doanh nghiệp cần yêu cầu đơn vị gia công cung cấp đầy đủ thông tin về công thức, hàm lượng từng hoạt chất, tránh các công thức “đóng gói sẵn” nhưng không rõ giá trị sinh học thực tế.
Có cam kết overage và kiểm nghiệm cuối hạn không?
Cam kết overage và kiểm nghiệm tại thời điểm cuối hạn sử dụng là yếu tố quan trọng để đảm bảo chất lượng sản phẩm không suy giảm theo thời gian, đồng thời giảm thiểu rủi ro hậu kiểm.
Có đánh giá nguy cơ tụt hàm lượng theo thời gian không?
Một đơn vị gia công chuyên nghiệp cần có phân tích rủi ro suy giảm hàm lượng, dựa trên đặc tính hoạt chất, công nghệ bào chế và điều kiện bảo quản.
Giá gia công thấp do tối ưu hay do cắt giảm giá trị sinh học?
Giá gia công thấp có thể đến từ việc tối ưu quy trình, nhưng cũng có thể là hệ quả của việc cắt giảm nguyên liệu, overage hoặc giải pháp ổn định. Doanh nghiệp cần phân biệt rõ hai trường hợp này trước khi ký hợp đồng.
Dịch vụ tư vấn kiểm soát TPBVSK là gì và vì sao ngày càng cần thiết?
Trong bối cảnh thị trường TPBVSK ngày càng cạnh tranh và bị giám sát chặt chẽ, dịch vụ tư vấn kiểm soát độc lập trở thành công cụ quan trọng giúp doanh nghiệp phát triển sản phẩm an toàn và bền vững.
Vai trò của tư vấn R&D - QC - QA độc lập
Tư vấn độc lập đóng vai trò đánh giá khách quan từ công thức, nguyên liệu đến quy trình sản xuất, giúp doanh nghiệp nhận diện sớm các điểm yếu về sinh học và chất lượng.
Không chỉ kiểm tra thành phẩm mà kiểm soát từ đầu
Thay vì chờ đến khi sản phẩm hoàn thiện mới kiểm tra, dịch vụ tư vấn kiểm soát tập trung can thiệp ngay từ giai đoạn R&D, nơi các quyết định sai lầm có thể gây hậu quả lớn về sau.
Giúp doanh nghiệp tránh sai ngay từ công thức
Kiểm soát từ đầu giúp doanh nghiệp tránh các sai sót mang tính hệ thống, giảm chi phí sửa sai, rút ngắn thời gian ra thị trường và nâng cao khả năng thành công dài hạn.
Vai trò của dịch vụ tư vấn kiểm soát TPBVSK đối với doanh nghiệp
Trong bối cảnh thị trường thực phẩm chức năng ngày càng cạnh tranh và chịu sự giám sát chặt chẽ, dịch vụ tư vấn kiểm soát TPBVSK không còn là lựa chọn bổ sung mà đã trở thành yếu tố chiến lược đối với doanh nghiệp muốn phát triển bền vững. Dịch vụ này giúp doanh nghiệp kiểm soát toàn diện từ công thức, nguyên liệu đến chất lượng thành phẩm, hạn chế rủi ro và tối ưu giá trị thực của sản phẩm.
Đảm bảo an toàn cho người tiêu dùng
Tư vấn kiểm soát giúp doanh nghiệp xác định và loại bỏ sớm các nguy cơ gây mất an toàn, như nhiễm tạp chất, kim loại nặng, vi sinh vượt ngưỡng hoặc hoạt chất không ổn định. Việc đảm bảo an toàn ngay từ đầu không chỉ bảo vệ sức khỏe người tiêu dùng mà còn giảm thiểu nguy cơ thu hồi và khiếu nại.
Đánh giá đúng hiệu quả và thành phần công bố
Một trong những vai trò quan trọng của tư vấn kiểm soát là đánh giá giá trị sinh học thực sự của công thức, đối chiếu giữa thành phần công bố và hiệu quả thực tế. Điều này giúp doanh nghiệp tránh tình trạng sản phẩm “đúng giấy tờ nhưng yếu tác dụng”, gây ảnh hưởng đến uy tín lâu dài.
Hỗ trợ tuân thủ pháp lý và hậu kiểm
Dịch vụ tư vấn kiểm soát giúp doanh nghiệp chủ động đáp ứng các yêu cầu pháp lý, từ hồ sơ công bố đến tiêu chuẩn kiểm nghiệm. Quan trọng hơn, doanh nghiệp được chuẩn bị sẵn sàng cho các đợt hậu kiểm, giảm nguy cơ bị xử phạt, đình chỉ hoặc thu hồi sản phẩm.
Xây dựng uy tín thương hiệu bền vững
Những sản phẩm được kiểm soát chặt chẽ về chất lượng và hiệu quả sẽ tạo dựng niềm tin dài hạn từ thị trường và người tiêu dùng. Đây là nền tảng để doanh nghiệp phát triển thương hiệu một cách bền vững, thay vì phụ thuộc vào truyền thông ngắn hạn.
Tối ưu chi phí thật, không chạy theo giá rẻ
Tư vấn kiểm soát giúp doanh nghiệp nhìn rõ bản chất chi phí, phân biệt giữa tối ưu hợp lý và cắt giảm giá trị sinh học. Nhờ đó, doanh nghiệp có thể kiểm soát ngân sách hiệu quả mà vẫn đảm bảo chất lượng sản phẩm.
Châu Khôi Pharma - Đơn vị tư vấn gia công TPBVSK khoa học & bền vững
Châu Khôi Pharma là đơn vị tư vấn chuyên sâu trong lĩnh vực gia công và kiểm soát chất lượng TPBVSK, định hướng phát triển sản phẩm dựa trên nền tảng khoa học, tác dụng sinh học thực và tính pháp lý bền vững.
Đội ngũ dược sĩ, tiến sĩ nhiều năm kinh nghiệm
Châu Khôi Pharma sở hữu đội ngũ dược sĩ và tiến sĩ giàu kinh nghiệm, am hiểu sâu về công thức, nguyên liệu và các tiêu chuẩn kiểm soát chất lượng trong ngành TPBVSK.
Tư vấn R&D gắn với tác dụng sinh học và pháp lý dài hạn
Thay vì chỉ tập trung vào hồ sơ công bố, Châu Khôi Pharma đặt tác dụng sinh học và tính ổn định dài hạn làm trọng tâm, giúp sản phẩm duy trì hiệu quả đến cuối hạn sử dụng và đáp ứng các yêu cầu pháp lý khắt khe.
Hỗ trợ từ công thức, QC, kiểm nghiệm đến công bố
Dịch vụ tại Châu Khôi Pharma bao phủ toàn bộ chuỗi giá trị sản phẩm, từ xây dựng công thức, kiểm soát QC, lựa chọn chỉ tiêu kiểm nghiệm đến hoàn thiện hồ sơ công bố, giúp doanh nghiệp tiết kiệm thời gian và giảm rủi ro.
Phù hợp doanh nghiệp muốn làm TPBVSK bài bản, không “ăn xổi”
Châu Khôi Pharma là lựa chọn phù hợp cho các doanh nghiệp hướng đến chiến lược phát triển dài hạn, mong muốn xây dựng sản phẩm TPBVSK chất lượng cao, minh bạch và bền vững, thay vì chạy theo xu hướng ngắn hạn.
Tóm lại, gia công TPBVSK giá rẻ không phải lúc nào cũng an toàn, dù sản phẩm có thể đáp ứng đầy đủ yêu cầu pháp lý ban đầu. Những rủi ro khi gia công thực phẩm chức năng thường không xuất hiện ngay, mà bộc lộ dần ở hiệu quả sinh học yếu, khó bán lại, nguy cơ hậu kiểm và tổn hại thương hiệu dài hạn. Doanh nghiệp muốn phát triển bền vững cần nhìn xa hơn giá gia công, tập trung vào giá trị sinh học thực sự, kiểm soát chất lượng xuyên suốt vòng đời sản phẩm và lựa chọn đơn vị tư vấn - gia công minh bạch, có năng lực R&D và QC chuyên sâu.
Những câu hỏi liên quan vấn đề giá gia công thấp đến từ đâu? Gia công tử tế khó hơn gia công rẻ ở điểm nào?
Gia công TPBVSK giá rẻ có an toàn không?
Gia công TPBVSK giá rẻ có thể đúng pháp lý nhưng không đảm bảo an toàn sinh học dài hạn. Nhiều sản phẩm vẫn đủ hồ sơ công bố nhưng hàm lượng hoạt chất không đạt ngưỡng sinh học hoặc suy giảm nhanh theo thời gian, tiềm ẩn rủi ro cho người dùng và doanh nghiệp.
Vì sao nhiều sản phẩm TPBVSK giá rẻ vẫn được cấp phép lưu hành?
Vì pháp luật kiểm soát hồ sơ và tiêu chuẩn tại thời điểm công bố, không đánh giá hiệu quả sinh học thực tế. Nếu công thức đạt giới hạn an toàn và đủ giấy tờ, sản phẩm vẫn được phép lưu hành dù hiệu quả thực tế thấp.
Rủi ro lớn nhất khi gia công thực phẩm chức năng giá rẻ là gì?
Rủi ro lớn nhất là suy giảm hàm lượng hoạt chất trước hạn sử dụng. Điều này khiến sản phẩm mất tác dụng thực tế, dễ bị khiếu nại, hậu kiểm và ảnh hưởng nghiêm trọng đến uy tín thương hiệu.
Gia công TPBVSK giá rẻ có ảnh hưởng đến khả năng bán lại sản phẩm không?
Có. Sản phẩm hiệu quả thấp thường không có tỷ lệ mua lại, buộc doanh nghiệp phụ thuộc vào quảng cáo mạnh, chi phí marketing cao và khó phát triển bền vững.
Gia công giá rẻ thường cắt giảm những yếu tố nào?
Thường cắt giảm overage, nguyên liệu chất lượng cao, giải pháp ổn định và kiểm nghiệm cuối hạn. Những yếu tố này không bắt buộc về mặt pháp lý nhưng quyết định hiệu quả sinh học thật của sản phẩm.
Không overage có vi phạm pháp luật không?
Không vi phạm pháp luật nhưng tiềm ẩn rủi ro đạo đức và chất lượng. Không overage khiến hàm lượng hoạt chất dễ tụt dưới mức công bố trước hạn sử dụng, làm sản phẩm “đúng luật nhưng không còn tác dụng”.
Sản phẩm TPBVSK giá rẻ có dễ bị hậu kiểm và xử phạt không?
Có nguy cơ cao hơn. Khi bị kiểm nghiệm tại thời điểm cuối hạn, nhiều sản phẩm giá rẻ không đạt hàm lượng công bố, dẫn đến cảnh báo, thu hồi hoặc xử phạt hành chính.
Làm sao để nhận biết gia công TPBVSK giá rẻ có rủi ro?
Doanh nghiệp cần kiểm tra công thức chi tiết, cam kết overage, kế hoạch kiểm nghiệm cuối hạn và đánh giá suy giảm hoạt chất theo thời gian. Nếu đơn vị gia công không minh bạch các yếu tố này, rủi ro là rất lớn.
Gia công TPBVSK an toàn có nhất thiết phải giá cao?
Không nhất thiết giá cao, nhưng không thể quá rẻ. Gia công an toàn là tối ưu chi phí dựa trên khoa học R&D và kiểm soát chất lượng, không phải cắt giảm giá trị sinh học.
Doanh nghiệp nên làm gì để giảm rủi ro khi gia công thực phẩm chức năng?
Nên có đơn vị tư vấn R&D - QC - QA độc lập ngay từ khâu xây dựng công thức. Điều này giúp tránh sai từ đầu, giảm rủi ro pháp lý và xây dựng sản phẩm bền vững 5-10 năm.
Gia công TPBVSK giá rẻ có phù hợp để xây dựng thương hiệu dài hạn không?
Không. Mô hình này chỉ phù hợp bán ngắn hạn, khó scale và dễ khủng hoảng. Thương hiệu bền vững cần sản phẩm có hiệu quả thật, không phụ thuộc hoàn toàn vào marketing.














